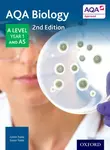
AQA Biology: A Level Year 1 and AS - Glenn Toole, Susan Toole

AQA Biology: A Level Year 1 and AS - Glenn Toole, Susan Toole

1 188,00 CZK
Průměrná cena
info
Levný
Drahý
Průměrná cena
1 135,71 CZK
Historické minimum
1 027,00 CZK
Popis produktu
Please note this title is suitable for any student studying:Exam Board: AQALevel: AS/A LevelSubject: BiologyFirst teaching: September 2015First exams: June 2017Fully revised and updated for the linear qualification, written and checked by curriculum and specification experts, this Student Book supports and extends students through the course whilst delivering the maths, practical and synoptic skills needed to succeed at A Level and beyond. The book uses clear straightforward explanations to develop true subject knowledge and allow students to link ideas together while developing essential exam skills.
Specifikace
- Stav: new
- Typ produktu:Knihy > Cizojazyčná literatura > English literature > Nonfiction
- GTIN/EAN: 9780198351764